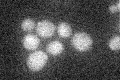
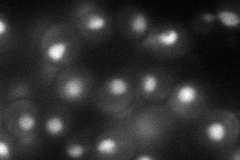

View description
F-box protein required for G1/S and G2/M transition, associates with Skp1p and Cdc53p to form a complex, SCFCdc4, which acts as ubiquitin-protein ligase directing ubiquitination of the phosphorylated CDK inhibitor Sic1p
Localization:
Intensity:
Fold change:
Significance:
-
C’ GFP library in SD
below threshold16.96 -
N' NOP1pr-GFP in SD
nucleus49.9406 -
N' TEF2pr-mCherry in SD

nucleus13.7634 -
N' NATIVEpr-GFP in SD

nucleus25.2947 -
N' TEF2pr-VC and Cyto-VN in SD

below threshold26.2658 -
C’ GFP library in SD+DTT

cytosol14.750.86No -
C’ GFP library in SD+H2O2

cytosol17.561.03No -
C’ GFP library in Starvation Media

cytosol17.21.01No -
C’ GFP library on the background of Pup2-DaMP

below threshold -
C’ GFP library on the background of CCT mutant

below threshold16.76660.988316No
